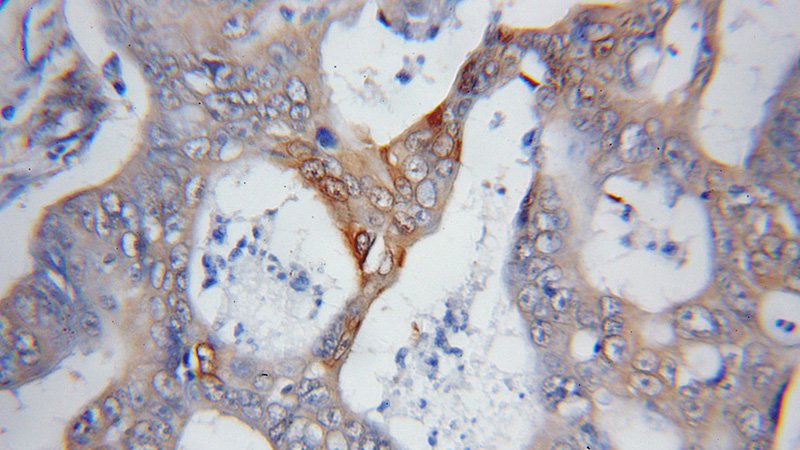
Immunohistochemical of paraffin-embedded human colon cancer using Catalog No:114397(PSMD14 antibody) at dilution of 1:50 (under 10x lens)

-
Product Name
PSMD14/POH1 antibody
- Documents
-
Description
PSMD14/POH1 Rabbit Polyclonal antibody. Positive IHC detected in human colon cancer tissue. Positive WB detected in human heart tissue, human brain tissue, mouse skeletal muscle tissue. Observed molecular weight by Western-blot: 35 kDa
-
Tested applications
ELISA, WB, IHC
-
Species reactivity
Human; other species not tested.
-
Alternative names
PAD1 antibody; POH1 antibody; PSMD14 antibody; rpn11 antibody
-
Isotype
Rabbit IgG
-
Preparation
This antibody was obtained by immunization of PSMD14/POH1 recombinant protein (Accession Number: BC009524). Purification method: Antigen affinity purified.
-
Clonality
Polyclonal
-
Formulation
PBS with 0.1% sodium azide and 50% glycerol pH 7.3.
-
Storage instructions
Store at -20℃. DO NOT ALIQUOT
-
Applications
Recommended Dilution:
WB: 1:200-1:2000
IHC: 1:20-1:200
-
Validations

human heart tissue were subjected to SDS PAGE followed by western blot with Catalog No:114397(PSMD14 antibody) at dilution of 1:400
Immunohistochemical of paraffin-embedded human colon cancer using Catalog No:114397(PSMD14 antibody) at dilution of 1:50 (under 10x lens)
-
Background
The PSMD14 (POH1, also known as Rpn11/MPR1/S13/CepP1) protein is a metalloprotease component of the 26S proteasome that specifically cleaves 'Lys-63'-linked polyubiquitin chains. The 26S proteasome is involved in the ATP-dependent degradation of ubiquitinated proteins. PSMD14 is highly expressed in heart and skeletal muscle. In carcinoma cell lines. down-regulation of PSMD14 by siRNA transfection had a considerable impact on cell viability causing cell arrest in the G0-G1 phase, ultimately leading to senescence.
-
References
- Wang B, Ma A, Zhang L. POH1 deubiquitylates and stabilizes E2F1 to promote tumour formation. Nature communications. 6:8704. 2015.
- Sparks A, Dayal S, Das J, Robertson P, Menendez S, Saville MK. The degradation of p53 and its major E3 ligase Mdm2 is differentially dependent on the proteasomal ubiquitin receptor S5a. Oncogene. 33(38):4685-96. 2014.
Related Products / Services
Please note: All products are "FOR RESEARCH USE ONLY AND ARE NOT INTENDED FOR DIAGNOSTIC OR THERAPEUTIC USE"
